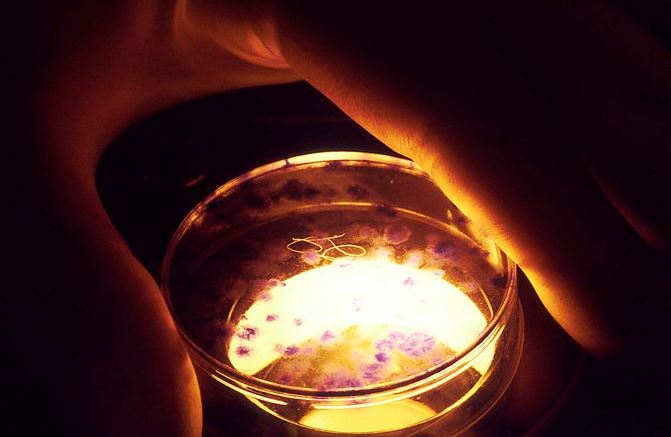

GENOVA. Sono state schedate in un atlante le proteine-spia dell’invecchiamento: le cellule che mostrano i primi segni di cedimento per l’età non hanno più segreti e conoscerle potrà accelerare la ricerca su una nuova generazione di farmaci anti-età. Chiamato Proteomic Atlas of Senescence-Associated Secretomes, l’atlante è stato pubblicato sulla rivista Plos Biology dal Buck Institute.
I ricercatori, guidati da Nathan Basisty e Birgit Schilling, hanno classificato le proteine spia dell’invecchiamento nell’uomo, chiamate Sasp (Senescence-Associated Secretory Phenotype), ottenendo la più ampia banca dati oggi disponibile. Hanno infatti decuplicato il numero delle proteine legate all’invecchiamento finora note, portandolo a oltre mille.
E’ noto da tempo che le cellule senescenti, che smettono di dividersi quando sono sotto stress, sono associate sia all’ invecchiamento, sia alla comparsa di diverse malattie. Il loro effetto, e quello delle proteine Saps che producono, è emerso nelle osservazioni fatte sui topi, tanto da indurre molte aziende farmaceutiche a sviluppare molecole capaci di contrastarle.
Tuttavia per sviluppare nuovi farmaci servono biomarcatori semplici e affidabili, che aiutino a valutare la presenza delle cellule senescenti nei tessuti umani. “La nostra speranza – commenta Schilling – è che l’atlante aiuti a identificare le proteine che inducono l’invecchiamento in modo da poter catalogare e sviluppare nuovi biomarcatori per valutare il peso e l’origine delle cellule senescenti in vivo“.
I risultati del Buck Institute sono stati validati anche dal Baltimore Longitudinal Study of Aging (Blsa), lo studio più ampio sui marcatori dell’invecchiamento, gestito dal National Institute on Aging (Nia) e condotto su 3.200 volontari.
Come degli investigatori molecolari, i ricercatori hanno catalogato i diversi tipi di morte cellulare sulla base delle diverse Sasp prodotte. “E’ un po’ come avere le impronte digitali dei diversi tipi di morte cellulare e per il futuro si può immaginare di avere dei biomarcatori che indichino lo stato e il tipo di invecchiamento quando la malattia ancora non è sviluppata o di verificare l’efficacia di farmaco”, spiega Angelo Reggiani, neurofarmacologo dell’Istitituto italiano di tecnologia (Iit) di Genova.